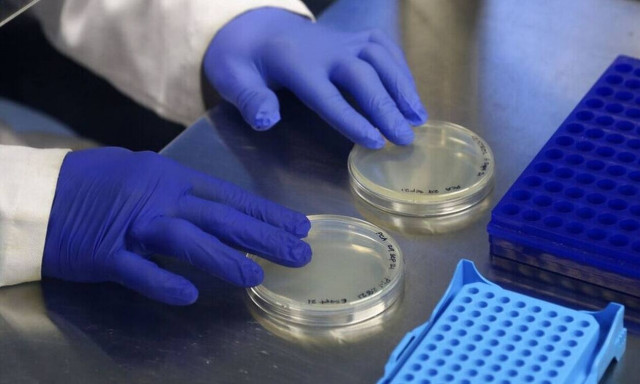
Δημόπουλος: H Όμικρον θα οδηγήσει σε αύξηση των διαγνώσεων μέσα στους επόμενους μήνες

ΜΕΤΑΛΛΑΞΗ ΟΜΙΚΡΟΝ
Η μετάλλαξη «Όμικρον» ή μετάλλαξη της Μποτσουάνα όπως έγινε αρχικά γνωστή είναι μια νέα μετάλλαξη του κορονοϊού που στα τέλη του Νοεμβρίου σήμανε νέο συναγερμό στον ΠΟΥ.
Το νέο στέλεχος ταυτοποιήθηκε για πρώτη φορά σε δείγματα ασθενών με COVID-19 που συλλέχθηκαν στις 11 Νοεμβρίου 2021 στη Μποτσουάνα, ενώ πολύ σύντομα ταυτοποιήθηκε και στη Νότια Αφρική καθώς και σε έναν εμβολιασμένο ταξιδιώτη που είχε επιστρέψει στο Χονγκ Κονγκ μετά από ταξίδι στη Νότια Αφρική κατά τα χρονικό διάστημα 22 Οκτωβρίου με 11 Νοεμβρίου 2021. Το στέλεχος Β.1.1.529 ανιχνεύτηκε και σε άλλο ένα άτομο στο ξενοδοχείο όπου διέμενε σε καραντίνα ο ταξιδιώτης με τον οποίο ήρθε σε επαφή.
Μετάλλαξη «Όμικρον»: Ποια συμπτώματα εμφανίζει
Μια Νοτιοαφρικανή γιατρός, υπεύθυνη για τη θεραπεία περίπου 30 ασθενών που φέρουν τη νέα παραλλαγή, είπε ότι, μέχρι στιγμής, έχει παρατηρήσει ανάρρωση των ασθενών χωρίς να χρειαστεί νοσηλεία.
Χαρακτηριστικά, υποστηρίζει για τα συμπτώματα ότι είναι «ήπια». Έπειτα από καμιά δεκαριά ημέρες, η Ανζελίκ Κέτζι, η οποία είναι επίσης πρόεδρος της Νοτιοαφρικανικής Ιατρικής Ένωσης, παρέλαβε αυτούς τους ασθενείς με θετικό τεστ στον κορονοϊό αλλά με ασυνήθιστα συμπτώματα. «Αυτό που τους έφερε στο γραφείο μου» στην Πρετόρια «είναι η αίσθηση υπερκόπωσης», είπε η ίδια στο AFP.
Μετάλλαξη «Όμικρον»: Πώς αντιδρά στα εμβόλια και στις θεραπείες
Οι επιστήμονες ανησυχούν διότι η B.1.1.529 «γεννά» περίπου 30 διαφορετικές μεταλλάξεις, αριθμός που είναι μεγαλύτερος από τις συνολικές μεταλλάξεις που προκαλεί η «Δέλτα». Το αν τα υπάρχοντα εμβόλια μπορούν να αντιμετωπίσουν και αυτή τη μετάλλαξη αποτελεί, προς το παρόν, ερωτηματικό. Είναι πιθανό αυτό το νέο στέλεχος να μπορεί να μολύνει άτομα που έχουν ανοσία σε προηγούμενες μεταλλάξεις.
Οι επιστήμονες πιστεύουν ότι τα προσφάτως εγκεκριμένα φάρμακα θα αποδειχθούν αποτελεσματικά, εμποδίζοντας την περαιτέρω διασπορά. Υπάρχει όμως περίπτωση τα μονοκλωνικά φάρματα να στοχεύουν σε τμήματα του ιού που έχουν ήδη μεταλλαχθεί.

Μετάλλαξη Όμικρον - Ατσαλάκης: Εξαπλώνεται με τετραπλάσια ταχύτητα

Μετάλλαξη Όμικρον: Σύσκεψη στο Μαξίμου υπό τον Κυριάκο Μητσοτάκη με τη συμμετοχή Τσιόδρα

Ολλανδία: Άδειοι εμπορικοί δρόμοι και πλατείες - Σε ισχύ από σήμερα το «σκληρό» εορταστικό lockdown

Κορονοϊός: Πόσο αξιόπιστα είναι τα rapid test για τη μετάλλαξη «Όμικρον»

Σαρηγιάννης στο Newsbomb.gr: Αυτά είναι τα μέτρα που θα «παγώσουν» τη μετάλλαξη Όμικρον

Κορονοϊός: To... φάντασμα του lockdown «στοιχειώνει» τα Χριστούγεννα στην Ευρώπη

Ανησυχία για τη μετάλλαξη «Όμικρον» - Σκέψεις για υποχρεωτικό τεστ

Μετάλλαξη «Όμικρον»: «Πολιορκεί» την Ιταλία - 83 κρούσματα έχουν καταγραφεί στη χώρα

Η μετάλλαξη Όμικρον «πνίγει» την Βρετανία - Έχουν εντοπιστεί 25.000 κρούσματα

Μετάλλαξη «Όμικρον» - «Καμπανάκι» ΠΟΥ: Εξαπλώνεται ραγδαία όπου υπάρχει μετάδοση

Γαλλία: Η «Όμικρον» ακύρωσε τις εορταστικές εκδηλώσεις για την Πρωτοχρονιά στην «Πόλη του Φωτός»

Μετάλλαξη «Όμικρον»: Αν η Ελλάδα δεν προχωρήσει σε «κλείσιμο» θα έχουμε «τσουνάμι» θανάτων

Γαλλία: Η μετάλλαξη «Όμικρον» εξαπλώνεται με ταχύτητα αστραπής - Σε συναγερμό ολόκληρη η Ευρώπη
Δημόπουλος: H Όμικρον θα οδηγήσει σε αύξηση των διαγνώσεων μέσα στους επόμενους μήνες

Πρασσάς: H «Όμικρον» θα φέρει άνοδο κρουσμάτων στην Ελλάδα - Τι συμβαίνει με τα εμβόλια

Λινού στο Newsbomb.gr: Μέχρι 10 Γενάρη η Όμικρον θα έχει επικρατήσει – Πόσο προστατεύουν τα εμβόλια

Κορονοϊός: Ποια είναι η αποτελεσματικότητα της τρίτης δόσης έναντι της «Όμικρον»

Κορονοϊός - Ολλανδία: Εισήγηση προς την κυβέρνησης για επιπλέον μέτρα, λόγω μετάλλαξης «Όμικρον»

Ακυρώνονται οι Χριστουγεννιάτικες εκδηλώσεις στην Γαλλία - Στον «κλοιό» της μετάλλαξης «Όμικρον»

Μετάλλαξη «Όμικρον»: «Κρύβεται» στην ελληνική επικράτεια - Άγνωστο ο ακριβής αριθμός των κρουσμάτων

Premier League: Συνάντηση των συλλόγων – Στο τραπέζι η αναβολή λόγω κορονοϊού

Μετάλλαξη Όμικρον: Πώς αλλάζει τα δεδομένα της πανδημίας του κορονοϊού - Τι προβλέπεται για το 2022

Τζανάκης στο Newsbomb.gr: Θέμα χρόνου να έχουμε «εκπλήξεις» με την Όμικρον – Μεταδίδεται αστραπιαία

Πούτιν: Το Sputnik V λειτουργεί καλύτερα απέναντι στην Omicron από τα άλλα εμβόλια







